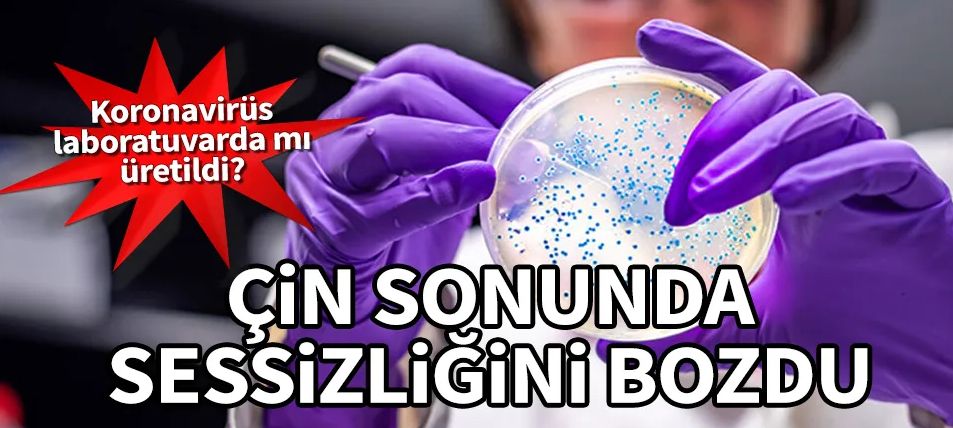

Vuhan'daki laboratuvar sessizliğini bozdu
ABD medyasının Kovid19'un Çin'in Vuhan kentindeki yüksek güvenlikli viroloji laboratuvarından yayıldığı iddialarına geniş yer vermesi, buna Nobel Tıp Ödüllü Fransız doktor Luc Montagnier'in destek vermesi ve Trump'ın rağbet etmesinin ardından, hedefteki kurum sessizliğini bozdu.
Çin devlet radyo televizyonu CGTN'ye konuşan Vuhan Viroloji Enstitüsü Başkan Yardımcısı Yuan Zhiming, suçlamaları "insanların kafasını karıştırmaya yönelik komplo teorisi" diye niteleyerek reddetti.
"Virüs araştırmaları yapan insanlar olarak enstitüde ne tür araştırmalar yürütüldüğünü, enstitünün virüsleri ve numuneleri nasıl kontrol ettiğini çok net biliyoruz. Baştan beri söylediğimiz gibi, virüsün bizden çıkmış olması ihtimali yok" diyen Vuhan Viroloji Enstitüsü Başkan Yardımcısı ekledi:
"Araştırmalarımız çok sıkı mevzuat rejimine ve mesleki ahlak kurallarına bağlıdır, o yüzden kendimizden eminiz."
CoronavirusPandemie: Labor in Wuhan wehrt sich gegen Vorwürfe tagesschau.de/ausland/corona… #Coronavirus #China
Yeni tip koronavirüsün laboratuvarda üretilmiş, yani insan yapımı olabileceği savını da reddeden Yuan Zhiming, bazı insanların pandemiyi Vuhan merkezli diye 44 milyon dolarlık laboratuvarla bağlantılandırdığını, ancak insanları kasten yanlış yönlendirmenin ahlaki olmadığını dile getirdi.
REPORT: Coronavirus Came From Wuhan Laboratory, Part Of China Trying To ‘Compete’ With America dailycaller.com/2020/04/15/cor…
ABD Başkanı Donald Trump, cuma günkü açıklamasında yönetiminin yeni tip koronavirüsün kökenlerini araştırdığını söyleyerek, bu meselenin etrafında 'çok sayıda acayip şeyin döndüğünü', Vuhan'daki laboratuvardan çıkmış olması ihtimalini 'mantıklı' bulduğunu dile getirmişti.
The lab in Wuhan being investigated as the source of the deadly coronavirus that spread to the world was given a grant by the Obama/Biden Administration. You can’t make this stuff up.
Öncesinde ABD'de hem Genelkurmay Başkanı hem de basın, istihbaratçıların bu ihtimali çok ciddi şekilde araştırdıklarını duyururken, Beyaz Saray'dan bir kaynak CNN'e "Ne zaman salgın patlak verse virüsün laboratuvardan kaçtığını söyleyen biri çıkar" demişti.
LAB LEAK? Sources Tell Fox News Coronavirus Could Have Escaped Chinese Laboratory in Wuhan hann.it/2XCDXVE
Ardından 2008'de Nobel Tıp Ödülü'nü alan Fransız doktor Luc Montagnier, yeni tip koronavirüsün Vuhan'da hayvan pazarından ortaya çıktığına inanmadığını söylemişti. Montagnier, "Kovid19, Vuhan'daki laboratuvardan üretildi. Bu laboratuvar, 2000'li yıllardan beri koronavirüs hakkında uzmanlaştı" demişti.
According to Professor Luc Montagnier, winner of the Nobel Prize for Medicine in 2008 for “discovering” HIV, the SARSCoV2 is a virus that was manipulated and accidentally released from a laboratory in Wuhan, China, in the last quarter of 2019.zerohedge.com/health/covid1…
Bunun üzerine Fransa Cumhurbaşkanı Emmanuel Macron'un ofisinden bir yetkili şu açıklamayı yapmıştı:
"Şunu netleştirmek isteriz ki, Kovid19'un kökenleri ie Vuhan'daki bir P4 laboratuvarının çalışmaları arasında bağlantı olduğuna dair son zamanlarda ABD medyasında dolaşımda olan enformasyonu teyit eden olgusal bir kanıt bugüne dek bulunamamıştır."
P4, salgın hastalıklar araştırmalarında en yüksek biyogüvenlik düzeyi anlamına geliyor.
Fransa 2004 yılında Çin'le Vuhan'da P4 laboratuvarı kurma konusunda anlaşma yapmıştı.
Önerilen Videolar
 Seçim propagandası özgürlüğü sona eriyor11 izlenme
Seçim propagandası özgürlüğü sona eriyor11 izlenme Sadece onlar 24 saat açık olacak! Tüm marketler 21.00'de kapanıyor8 izlenme
Sadece onlar 24 saat açık olacak! Tüm marketler 21.00'de kapanıyor8 izlenme-
Reklamlar
 Madenciler yine Ankara yolunda! Otobüsleri 3 kez iptal ettirildi3 izlenme
Madenciler yine Ankara yolunda! Otobüsleri 3 kez iptal ettirildi3 izlenme Kraliçe Elizabeth'in Cenazesi için Antalya ve Isparta'da Karanfil Mesaisi! Çalışma saatleri ve işçi sayısı arttırıldı.9 izlenme
Kraliçe Elizabeth'in Cenazesi için Antalya ve Isparta'da Karanfil Mesaisi! Çalışma saatleri ve işçi sayısı arttırıldı.9 izlenme Uluslararası Hava Taşımacılığı Birliği: Yılın ikinci yarısında hava yollarının dakikada 300 bin dolar kaybetmesini bekliyoruz18 izlenme
Uluslararası Hava Taşımacılığı Birliği: Yılın ikinci yarısında hava yollarının dakikada 300 bin dolar kaybetmesini bekliyoruz18 izlenme Kuyumcular da kepenk kapattı!11 izlenme
Kuyumcular da kepenk kapattı!11 izlenme İkinci Çakır vakası Sivas'ta yaşandı! Sivaslılar ‘Saadettin Köpek’e pusu kurmak için belediyeden otobüs istedi!17 izlenme
İkinci Çakır vakası Sivas'ta yaşandı! Sivaslılar ‘Saadettin Köpek’e pusu kurmak için belediyeden otobüs istedi!17 izlenme 15 Temmuz'da Ulusal Kanal: Türkiye darbeyi yapanın FETÖ olduğunu bizden öğrendi9 izlenme
15 Temmuz'da Ulusal Kanal: Türkiye darbeyi yapanın FETÖ olduğunu bizden öğrendi9 izlenme
Bunlar da İlginizi Çekebilir
 Bakan Koca açıkladı: 66.237 yeni vaka tespit edildi, 34.592 kişi sağlığına kavuşurken, 141 kişi hayatını kaybetti!
Bakan Koca açıkladı: 66.237 yeni vaka tespit edildi, 34.592 kişi sağlığına kavuşurken, 141 kişi hayatını kaybetti!  Türk Konseyi'nden olağanüstü toplantı! Ortak bildiri yayımlandı
Türk Konseyi'nden olağanüstü toplantı! Ortak bildiri yayımlandı  Allah’ın Kulunu Sevdiğinin 5 İşareti
Allah’ın Kulunu Sevdiğinin 5 İşareti  Bilim insanlarından ezber bozan araştırma! Mutasyona uğrayan koronavirüs zayıflar mı güçlenir mi?
Bilim insanlarından ezber bozan araştırma! Mutasyona uğrayan koronavirüs zayıflar mı güçlenir mi?









